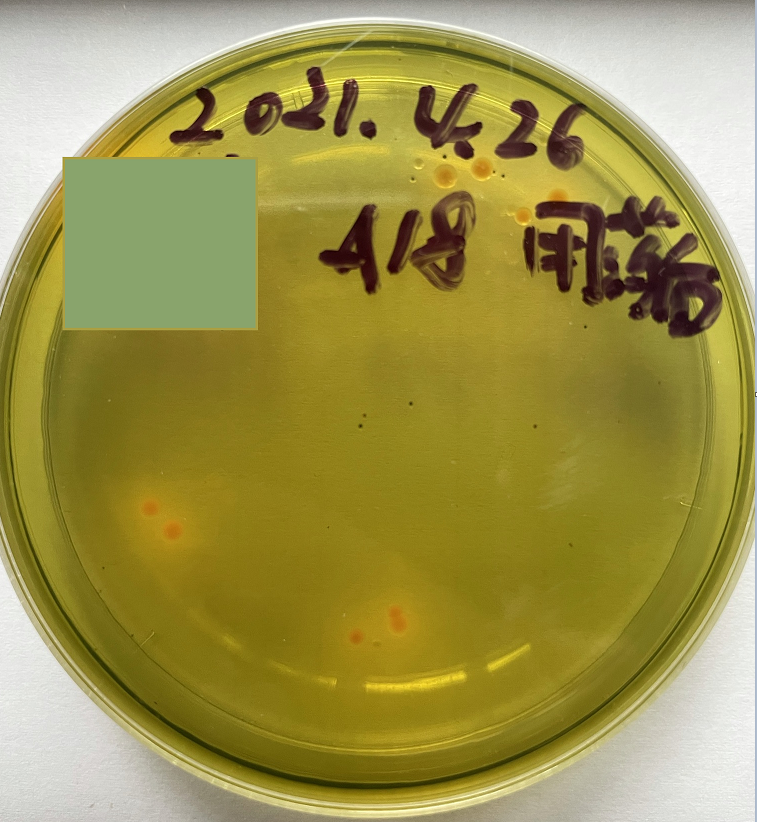

今年以来,各地苗场陆续出现虾苗空肠空胃、白苗、玻璃苗等病情,发病率高、传染性强,部分苗场甚至自连续3-4批苗全部排掉。中询生物蛭弧菌专家技术团队在广东沿海地区开展病情防治工作,效果显著。
此次虾苗病情集中表现的症状包括哪些?
症状在标苗阶段高发。典型病情包括:
(1) 在虾苗进场后1-2天内,出现红头、红肠症状,如下图

(2) 在标苗第4-5天开始,空肠空胃率开始激增,苗体通体发白或透明,苗池内虾苗发育尺寸差异大(见下图)。
(3) 发病苗池陆续出现大量掉苗,在3-4天内,整批次虾苗均出现病情,无奈排苗。
致病原因是什么?
我们关注几个集中的现象:
(1) 此次防治过程中,虾苗未检测出白斑、虹彩等常见病毒,但虾苗体内弧菌量大。
(2) 发病主要集中在标苗阶段,且自标苗开始即出现症状。
推测发病原因为:虾苗在育苗期间,体内已有大量弧菌,由于运输(自育苗场到标苗厂运输过程)期间环境不稳定、标苗环境变化(淡化等环节)产生应激,诱发体内弧菌感染,致弧菌病爆发。
弧菌专家最近两个月来防治此次虾苗疾病效果如何?
中询生物弧菌专家在汕尾、湛江、珠海等地区育苗、标苗车间开展弧菌病防治。实现:
(1) 使用2-3餐,杀灭体内弧菌,如下图。
(2) 采用弧菌专家育苗、标苗弧菌病防治模式的,100%成功预防上述病情。
弧菌病如何防治?中询蛭弧菌能够快速精准的识别弧菌,并以无鞭毛端为先导,接触弧菌后快速旋转,通过弧菌细胞壁进入周质空间,然后使其膨胀成球状蛭弧体,短时间内就可完成繁殖并破裂弧菌胞体,释放到水中的新生蛭弧菌进入下一个裂解弧菌的循环。中询蛭弧菌可全天候使用,不受天气、溶氧、有机物、水质和pH值等环境因素影响。不对水体有益菌、藻类、浮游生物、养殖水生动物有影响。对因弧菌引起的白便、拖便、肠炎、肝胰腺病变、红须、红尾、红腿、行动迟缓、吃料减慢有显著效果。
为什么能取得这么好的效果?
第一、 弧菌专家快速抑杀虾苗体内弧菌,使用2-3餐,检测,体内弧菌基本被抑杀,从病根入手防治病情出现或扩散。
第二、 弧菌专家可提高虾苗肝胰腺酶活性,提高虾苗抵抗力,防治病情复发或环境中弧菌再次侵入虾体,造成感染。
第三、稳消毒,使用50%的塘宁散可以快速杀灭池塘中的包括弧菌在内的细菌。
第四、勤改底,弧菌喜欢生长在池塘底部有机质多的环境中,池塘底部的残饵粪便都是弧菌喜欢附着生长的场所,经常用底宁片改底可以氧化底部有机质,破坏弧菌生长的环境。
第五、多增氧,弧菌是厌氧细菌,也就是说水质越脏,池塘溶氧不好,弧菌越多。池塘底部充足的氧气含量可以抑制弧菌的生长。
弧菌专家在种苗期使用的模式是怎样的?
育苗期,在P3-P4期间使用2-3餐弧菌专家IV、V号,在育苗出苗前(起运至标苗厂前)用一餐。
标苗期:在进苗后第2餐起,连续使用2-3餐,在出苗前使用一餐。
有什么需要注意的问题?
一旦已经发生肝胰腺病变,白便,就很难逆转,水产养殖以防为主。
此次弧菌病病情发病急,2-3天可能导致大量死亡,故因及早进行防治。实验表明,当空肠空胃率>20%后,采取防治措施只能减缓病情发展,但无法治愈或遏制病情扩散。在标苗或育苗开始阶段,及早使用弧菌专家进行弧菌病防治,可有效避免发病,省钱、省力、省心。